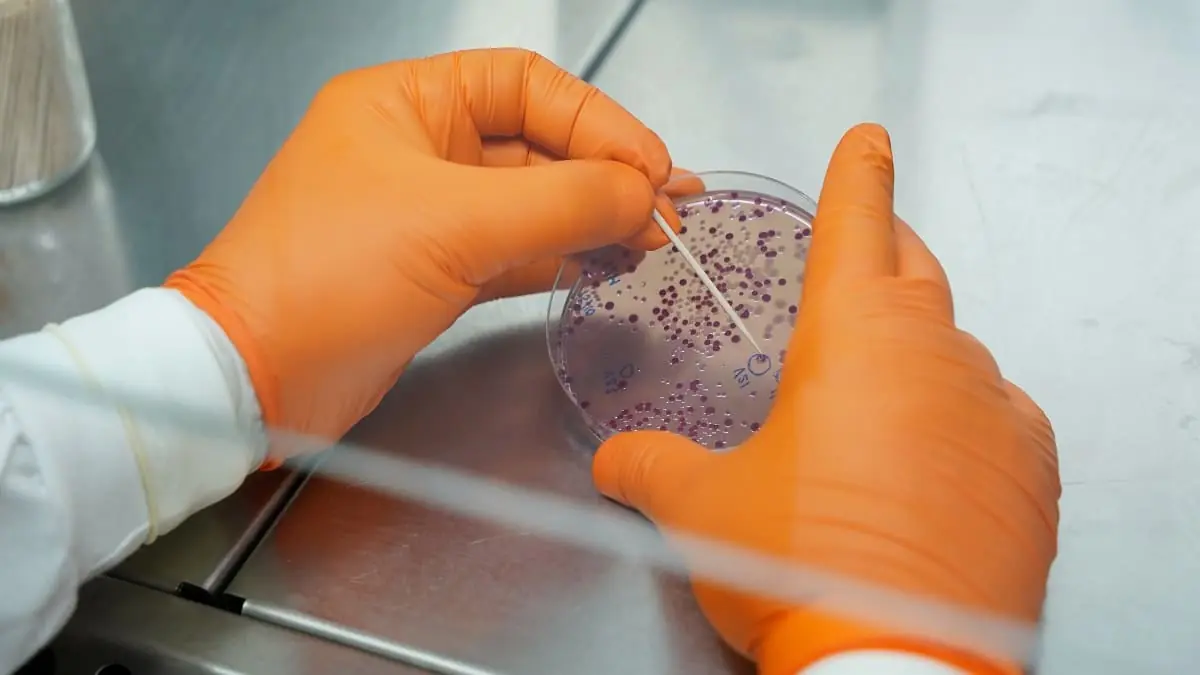

La cadena alimentaria está considerada como una de las vías potenciales de transmisión y propagación de microorganismos resistentes a antibióticos. En AINIA, a través del proyecto RAMDETEC con el apoyo de IVACE y fondos FEDER, hemos desarrollado herramientas avanzadas enfocadas a la detección de forma completa y precisa de estos microorganismos en alimentos. Este avance refuerza el control microbiológico en la industria y abre nuevas oportunidades de aplicación en calidad y seguridad alimentaria.
La resistencia frente a antibióticos y antimicrobianos, conocida como RAM, representa un desafío global cada vez más grave, y no sólo por su impacto en el ámbito clínico, sino también por el modo en que se propaga a través de la cadena alimentaria mediante el consumo o manipulación de alimentos contaminados. Esta situación exige una respuesta urgente del sector agroalimentario, que debe reforzar los controles microbiológicos para frenar la propagación de estas resistencias y proteger la salud pública.
Con el proyecto RAMDETEC, desarrollado por AINIA con el apoyo del Instituto Valenciano de Competitividad Empresarial (IVACE) y fondos FEDER, hemos dado un paso adelante en esta dirección. El objetivo del proyecto ha sido desarrollar metodologías avanzadas para la detección de forma rápida, completa y precisa de RAM en alimentos. Para ello, nos hemos centrado en matrices alimentarias especialmente relevantes por su susceptibilidad a la contaminación de microorganismos resistentes: carne de pollo, carne de vacuno, productos vegetales de consumo cultivados en el suelo como la sandía, la lechuga y la calabaza, y agua empleada en sistemas de regadío.
En el siguiente vídeo te mostramos cómo, desde AINIA, hemos aplicado estas metodologías para el análisis de RAM. A través del proyecto RAMDETEC, combinamos ciencia, tecnología y colaboración empresarial para avanzar en la lucha frente a este tipo de resistencias en la cadena alimentaria:
Metodologías avanzadas para el análisis de RAM en alimentos
En la actualidad, las técnicas reconocidas en Europa para detectar la resistencia a los antimicrobianos en los controles oficiales de la cadena agroalimentaria se basan, principalmente, en métodos que evalúan cómo responde un microorganismo aislado a distintas concentraciones de un antibiótico, como es el caso del método de microdilución (ISO 20776-2). Aunque estos procedimientos son útiles, son lentos, ya que exigen aislamiento y cultivo, y, además, ofrecen información limitada sobre los mecanismos específicos de resistencia, lo que dificulta una identificación rápida y precisa de las amenazas presentes.
Por este motivo, en RAMDETEC hemos desarrollado metodologías innovadoras que permiten un análisis de RAM en alimentos con mayor rapidez y precisión, además de proporcionar una información más completa de las resistencias. Este proyecto se ha centrado principalmente en Escherichia coli BLEE, bacteria muy conocida por su resistencia antimicrobiana de amplio espectro debido a la producción de enzimas betalactamasas.
Además de trabajar con el método de microdilución, método de referencia en los controles oficiales, en el marco del proyecto RAMDETEC hemos puesto a punto las siguientes metodologías para el análisis de RAM:
- qPCR, técnica de biología molecular que nos ha permitido la detección dirigida y con elevada sensibilidad de la presencia de material genético de bacterias RAM en las matrices alimentarias estudiadas.
- Secuenciación masiva o NGS (Next-Generation Sequencing), tecnología ómica que nos ha proporcionado información completa y detallada acerca de la comunidad microbiana y de los perfiles genéticos de resistencia presentes en las muestras.
- MALDI-TOF-MS, tecnología que hemos explorado para la identificación de microorganismos RAM a partir del perfil de péptidos y proteínas. Cabe puntualizar que hemos observado que, si bien es una tecnología tremendamente útil en la identificación rápida y precisa de microorganismos aislados en placa, su implementación en la identificación de resistencias resultaría extraordinariamente compleja y no parece ofrecer ventajas adicionales respecto al resto de metodologías estudiadas.
Avances clave del Proyecto RAMDETEC
En AINIA, a través del proyecto RAMDETEC, hemos desarrollado metodologías innovadoras para el análisis de RAM que, aunque aún no forman parte de los controles oficiales en la industria agroalimentaria, representan una gran oportunidad para su futura implantación debido a su mayor precisión, rapidez y capacidad para detectar resistencias específicas. Estas nuevas herramientas podrán marcar un antes y un después en la vigilancia de la RAM, facilitando un control más eficiente a lo largo de toda la cadena alimentaria.
Estas metodologías, además, han sido evaluadas y validadas frente a la norma de referencia ISO 20776-2, aplicando las indicaciones de la norma ISO 16140, orientada a la validación de técnicas alternativas para los análisis microbiológicos en la cadena alimentaria. Para ello, ha sido clave la colaboración de empresas del sector agroalimentario de la Comunitat Valenciana, las cuales nos han proporcionado los productos estudiados en el proyecto. Esta colaboración ha permitido no sólo verificar la eficacia del enfoque desarrollado, sino también aportar un valor añadido a los productos de estas empresas.
Más allá de su impacto en la industria agroalimentaria, los resultados del proyecto RAMDETEC abren nuevas líneas de trabajo en el análisis de la resistencia a los antimicrobianos con posibilidad de aplicación en multitud de sectores, como en medioambiente, higiene, sanidad animal o salud pública, donde la detección temprana y precisa de resistencias resulta clave para prevenir su propagación y proteger la salud de las personas, los animales y los ecosistemas en un enfoque integral One Health.